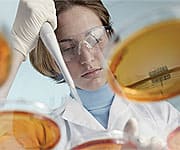
image

Life Extension Magazine®
New studies suggest the key to staying mentally sharp as you grow older may be as simple as including more blueberries in your daily diet. A rich source of disease-fighting antioxidants, blueberries have demonstrated a remarkable ability to reverse the effects of aging on the brain, helping to restore memory and cognition to a more youthful state. Blueberries also appear to help ward off deadly cancers, while protecting cells against damage incurred by diabetes. Blueberries may even help prevent bothersome urinary tract infections. In short, incorporating these delicious, nutritious berries in your diet may provide a wealth of important health benefits. Rich Source of Antioxidant PolyphenolsNative to North America, blueberries have long been used in food preparation and for therapeutic purposes.1 Modern research confirms that this fruit is one of the most nutritious foods available today. Many of the health benefits attributed to blueberries have been linked to their potent antioxidant properties. When the United States Department of Agriculture (USDA) compared the antioxidant capacity of more than 20 different fruits, blueberries were at the top of the list. The study found that a one-cup serving of wild blueberries had more antioxidant capacity than a comparable serving of cranberries, strawberries, plums, or raspberries. Moreover, the antioxidant capacity of wild blueberries was 48% higher than that of cultivated blueberries.2 Scientists attribute these powerful antioxidant properties to polyphenols in blueberries known as anthocyanins, deep blue-purple pigments that confer strong anti-inflammatory as well as antioxidant effects.3 Demonstrated Effects in Delaying Brain AgingHuman aging is associated with the accumulation of oxidative damage to cells. Such damage may ultimately lead to conditions such as Alzheimer’s disease, cancer, and cardiovascular disease, which share the common thread of inflammation. Maintaining an ample intake of antioxidants such as antho-cyanins is an important strategy for protecting delicate cells against the oxidative damage that accrues over time.4
Blueberry’s effects in slowing human aging are most extensively documented in studies of the central nervous system. The brain is particularly sensitive to free-radical-induced damage, oxidative stress, and impaired supply of essential blood and oxygen, which can lead to memory and motor impairment, and even neuro-degenerative disorders such as Parkinson’s disease. Fortunately, blueberries may help protect the brain against such damage. Blueberry polyphenols help reduce inflammatory responses in essential brain cells, and could be potentially useful in modulating inflammatory conditions in the brain.5,6 Blueberries have been found to improve many of the changes in cognitive function that commonly occur with aging.5,6 For example, scientists believe blueberries help reverse age-related decline in nerve-cell signaling, preserving the cells’ ability to communicate with each other over time.5-7 Scientists at the USDA Human Nutrition Research Center on Aging found that blueberries helped improve motor skills and reverse short-term memory loss in an animal model of age-related cognitive decline. After two months of blueberry consumption, animals showed improved navigational skills.7 Other studies have shown that a diet rich in blueberries is associated with an enhanced ability to learn via certain brain pathways.8 Additional research suggests that consuming wild blueberries may help protect the brain against brain cell death due to ischemic stroke, which occurs when the brain is deprived of blood and oxygen, and can produce lasting damage to the nervous system.9 Benefits Against Cancer, Diabetes, and MoreEmerging studies suggest that blueberries may help protect against deadly cancers and diabetes, while improving the health of urinary tract.
In the laboratory, extracts of blueberries and other commonly consumed berries showed efficacy in killing oral, breast, and prostate cancer cells.10 In the laboratory, blueberry anthocyanins have been found to induce programmed cell death (apoptosis) in cancer cells.11 A recent study suggests that pterostilbene, a phenolic compound present in blueberries, may help prevent colon cancer.12 Laboratory studies show that blueberries contain active compounds with insulin-like properties, and may protect cells against the toxic effects of excess glucose. These findings are leading scientists to regard blueberry extracts as promising complementary therapeutics in averting the consequences of diabetes.13 Intriguing research also suggests that blueberries may also help prevent troublesome bladder infections. Like cranberries, blueberries contain compounds that prevent E. coli bacteria (which are responsible for most urinary tract infections) from attaching to the bladder wall. No longer able to cling to the bladder’s lining, these bacteria can then be flushed out of the body.14 Enjoying BlueberriesA delicious and versatile fruit, blueberries can be enjoyed by the handful and make a wonderful addition to cereals, pancakes, salads, and baked goods such as pies. For maximum benefit (and best taste), store ripe blueberries in a covered container in the refrigerator and eat them within a week. Avoid washing blueberries until just before eating, as washing removes the “bloom” that protects the fruit’s skin from degradation.1
| |||||
| References | |||||
| 1. Prett S, Matthews K. Super Foods: Fourteen Foods That Will Change Your Life. New York, NY: Harper Collins; 2005:52. 2. Wu X, Beecher GR, Holden JM, et al. Lipophilic and hydrophilic antioxidant capacities of common foods in the United States. J Agric Food Chem. 2004 Jun 16;52(12):4026-37. 3. Kalt W, Ryan DA, Duy JC, et al. Interspecific variation in anthocyanins, phenolics, and antioxidant capacity among genotypes of highbush and lowbush blueberries (Vaccinium section cyanococcus spp.). J Agric Food Chem. 2001 Oct;49(10):4761-7. 4. Wilson MA, Shukitt-Hale B, Kalt W, et al. Blueberry polyphenols increase lifespan and thermotolerance in Caenorhabditis elegans. Aging Cell. 2006 Feb;5(1):59-68. 5. Lau FC, Bielinski DF, Joseph JA. Inhibitory effects of blueberry extract on the production of inflammatory mediators in lipopolysaccharide-activated BV2 microglia. J Neurosci Res. 2007 Apr;85(5):1010-7. 6. Lau FC, Shukitt-Hale B, Joseph JA. The beneficial effects of fruit polyphenols on brain aging. Neurobiol Aging. 2005 Dec;26 Suppl 1:128-32. 7. Joseph JA, Denisova NA, Arendash G, et al. Blueberry supplementation enhances signaling and prevents behavioral deficits in an Alzheimer disease model. Nutr Neurosci. 2003 Jun;6(3):153-62. 8. Shukitt-Hale B, Carey AN, Jenkins D, Rabin BM, Joseph JA. Beneficial effects of fruit extracts on neuronal function and behavior in a rodent model of accelerated aging. Neurobiol Aging. 2006 Jul 10; [Epub ahead of print]. 9. Sweeney MI, Kalt W, MacKinnon SL, Ashby J, Gottschall-Pass KT. Feeding rats diets enriched in lowbush blueberries for six weeks decreases ischemia-induced brain damage. Nutr Neurosci. 2002 Dec;5(6):427-31. 10. Seeram NP, Adams LS, Zhang Y, et al. Blackberry, black raspberry, blueberry, cranberry, red raspberry, and strawberry extracts inhibit growth and stimulate apoptosis of human cancer cells in vitro. J Agric Food Chem. 2006 Dec 13;54(25):9329-39. 11. Srivastava A, Akoh CC, Fischer J, Krewer G. Effect of anthocyanin fractions from selected cultivars of Georgia-grown blueberries on apoptosis and phase II enzymes. J Agric Food Chem. 2007 Apr 18;55(8):3180-5. 12. Suh N, Paul S, Hao X, et al. Pterostilbene, an active constituent of blueberries, suppresses aberrant crypt foci formation in the azoxymethane-induced colon carcinogenesis model in rats. Clin Cancer Res. 2007 Jan 1;13(1):350-5. 13. Martineau LC, Couture A, Spoor D, et al. Anti-diabetic properties of the Canadian lowbush blueberry Vaccinium angustifolium Ait. Phytomedicine. 2006 Nov;13(9-10):612-23. 14. Schmidt BM, Howell AB, McEniry B et al. Effective separation of potent antiproliferation and antiadhesion components from wild blueberry (Vaccinium angustifolium Ait.) fruits. J Agric Food Chem. 2004 Oct 20;52(21):6433-42. 15. Murray M, Pizzorno J. Encyclopedia of Healing Foods. New York, NY: Atria Books; 2005:260. 16. Available at: http://www.nutritiondata.com/facts-C00001-01c20Tr.html. Accessed April 19, 2007. |